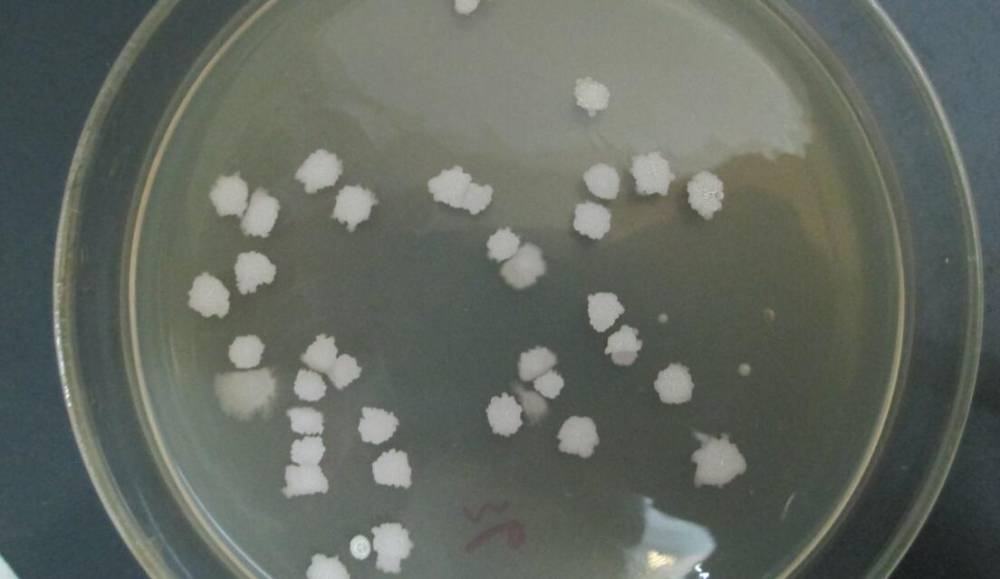

| 产品特性:水溶菌粉 | 是否进口:否 | 产地:中国 |
| 主要成分:枯草芽孢杆菌 | 含量≥:1000亿/克% | 适用范围:肥料添加、植物护理 |
| 货号:HH-KC1000 | 水分 ≤:10% | 外观:淡黄色至黄褐色 |
| 生产厂家:国内源头厂家 | 新奇创意项目:不报名 | 品牌:惠禾 |
| 肥料登记证件号: 在线客服 |
惠禾 枯草芽孢杆菌 1000亿/克 全水溶 肥料功能菌添加 生物菌肥
【主要成份】枯草芽孢杆菌、可溶载体
【技术指标】有效活菌数≥1000亿/克
【产品特性】
1. 菌种纯、芽孢数高、杂菌率低;
2. 耐高温,在造粒烘干过程中不易失活。
【产品功能】
1. 提高和延长肥效,减少化学肥料的用量;
2. 促进植物生长,预防植物病害;
3. 改良土壤,修复微生态平衡;
4. 提高农产品品质。
【作用机理】
1. 竞争作用
枯草芽孢杆菌通过对营养物质的争夺、物理和生物学位点的抢夺等方式控制植物病原微生物的发展。竞争作用是生防微生物发挥作用的重要机制之一,涉及生防微生物在植物根际或体表或体内的定殖、繁殖与种群的建立及与病原微生物的相互作用。
2. 拮抗作用
枯草芽孢杆菌通过同化作用产生抗菌物质抑制有害病原物的生长或直接杀灭病原物。
3. 促进植物生长
枯草芽孢杆菌能促进植物根系及植株生长,增强了植物的抗病性,从而间接地减少病害发生。
4. 释放磷钾
通过把无效磷、钾转化为有效磷和有效钾,有效提高土壤中磷和钾的吸收率。
【用法用量】肥料添加,每吨肥料添加200-300克
【包装规格】25kg/包
【贮存条件】阴凉、干燥、避光处贮存
【保质期】18个月
【注意事项】
1.本品不能替代农药;
2.可减少化肥用量,但不能完全替代化肥。
供应商信息
| 企业类型 | 有限责任公司(自然人独资) | 注册资本 | 50.00万人民币 |
| 公司注册地址 | 广州市黄埔区科学大道112号1909房 | 统一社会信用代码 | 91440101MA9UQAEU4W |
| 登记机关 | 广州市黄埔区市场监督管理局 | 法定代表人 | 许小穗 |
| 公司成立日期 | 2020-08-05 | 营业期限 | 2020-08-05 至 无固定期限 |
| 经营范围 | 水产业科学研究服务;畜牧业科学研究服务;林业科学研究服务;农业科学研究和试验发展;食品添加剂批发;食品添加剂零售;生物防治技术开发服务;生物防治技术咨询、交流服务;生物防治技术转让服务;有机肥料及微生物肥料批发;有机肥料及微生物肥料零售;农业技术推广服务;生物技术开发服务;生物技术推广服务;生物技术转让服务;生物技术咨询、交流服务;饲料添加剂批发;饲料添加剂零售;;非酒精饮料、茶叶批发;非酒精饮料及茶叶零售; | ||
产品推荐
推荐产品
本页信息为广州惠禾生物科技有限公司为您提供的"惠禾 枯草芽孢杆菌 1000亿/克 全水溶 肥料功能菌添加 生物菌肥"产品信息,如您想了解更多关于"惠禾 枯草芽孢杆菌 1000亿/克 全水溶 肥料功能菌添加 生物菌肥"价格、型号、厂家请联系厂家,或给厂家留言。 进入店铺
在线留言